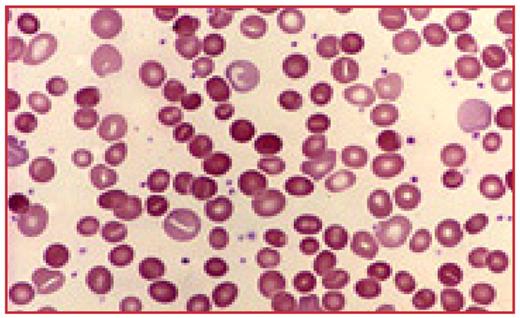
Figure 1:. Peripheral Blood smear showing anisopoikilocytosis & spherocytosis.

Abstract
Introduction: Anemia is a common problem in patients with inflammatory bowel diseases (IBD), and its etiology is usually multifactorial. It can be produced by chronic blood loss, nutritional deficiencies, and drugs such as salazopyrine; however it can also due to auto immune hemolysis, which is a rare complication of IBD. We report a case of coombs positive autoimmune hemolytic anemia associated with ulcerative colitis both diagnosed at the same presentation.
Case Report: A 32 year old man with no significant past medical history presented with complaint of dark colored urine, jaundiced skin and fatigue for 4 weeks. He also reported diarrhea mixed intermittently with blood for last few months. Physical exam was consistent with jaundice and anemia (pallor and icterus) with slightly palpable spleen. Initial lab work up showed Hb of 3.8 with normal platelet and WBC count, high reticulocytes count of 7% .LFT showed serum bilirubin of 3.6 (direct 0.4) with normal serum ALT and AST levels .Serum LDH was high (1032 U/l) while serum haptoglobin was low (0.11 mg/dl). Peripheral smear showed anisopoikilocytosis & spherocytosis. (See Figure 1) Further investigations revealed a positive direct Coombs test consistent with diagnosis of autoimmune hemolytic anemia. CT abdomen and pelvis showed mild splenomegaly & non-specific enlarged mesenteric lymph nodes. Colonoscopy revealed ulcerative pancolitis confirmed by histological findings of biopsies taken. Patient received PRBC transfusions and was started on steroids and mesalamine and was discharged on maintenance dose. His symptoms resolved in 4 weeks and Hb remained stable with no evidence of further hemolysis at 4 month follow up .Repeated CT abdomen & pelvis showed resolution of the lymphadenopathy.
Peripheral Blood smear showing anisopoikilocytosis & spherocytosis.
Peripheral Blood smear showing anisopoikilocytosis & spherocytosis.
Discussion: Autoimmune hemolytic anemia (AIHA) is a rare complication of IBD. The exact underlying pathogenesis of this association remains obscure; however it has been attributed to the production of cross reacting anti erythrocyte antibodies. In AIHA associated with IBD, corticosteroids are considered to be first line therapy and often cause remission of hemolysis along with treatment for IBD Immunomodulators and splenectomy has been used for patients with refractory AIHA. Colectomy done for fulminant colitis has also been reported to induce remission of AIHA. Further studies for long term follow up and pathogenesis of this association are warranted.
Disclosures: No relevant conflicts of interest to declare.
Author notes
Corresponding author
This feature is available to Subscribers Only
Sign In or Create an Account Close Modal